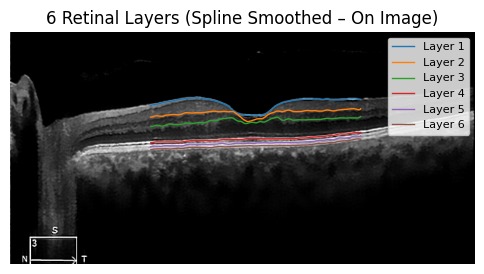

Lightweight Retinal Layer Segmentation ML Model
This research proposes a column-wise intensity-based deep learning approach for retinal OCT layer segmentation, using denoising, CNN-BiLSTM modeling, and custom loss functions to accurately detect and reconstruct six retinal layers. The lightweight model is optimized for deployment on edge devices while maintaining high accuracy in medical image analysis.
Project Gallery

Image 1
Add image to: /projects/retinal-segmentation/image1.jpeg

Image 2
Add image to: /projects/retinal-segmentation/image2.jpeg
Image 3
Add image to: /projects/retinal-segmentation/image3.jpeg
All images © 2026 Yehan Sajana
Key Features & Highlights
Other Projects
Amphibious Robot for Wildlife Exploration
A multi-terrain amphibious robot equipped with tracks and four independently powered wheels for wildlife exploration and environmental monitoring.
Single Wheeled Yaw Controlled Robot
A single-wheel 360° yaw-controlled balancing robot developed for advanced balancing and maneuverability research.
Diyakawa 1.0 Underwater Robot
A fully submersible underwater robot designed and developed for the IEEE Singapore AUV Challenge 2024, securing 11th place overall.